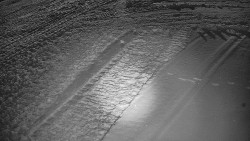
Otočná kamera na sjezdovce

Městys Nedvědice
Pohled na hrad Pernštejn od městysu Nedvědice
Chata na Grúni
Pohled od chaty na Grúni směrem na Poludňový grúň.
Město Cres
Pohled na městský přístav a městečko Cres.
Ski Areál Opálená
Na snímku z kamery je sjezdovka ski areálu Opálená
Ski areál Razula
Pohled na sjezdovku Horal a na areál golfového hřiště.
Město Zlaté Hory
Celkový pohled na město Zlaté Hory z rozhledny na Biskupské kupě. Biskupská
Město Buchlovice
Pohled na náměstí Svobody v Buchlovicicíh, v pozadí hřeben Chříbů s Buchlovským hradem.
Městečko Mariazell
Pohled na basiliku v centru městečka Mariazell
Obec Veselíčko
Kamera na jedné ze zámeckých věži v obci Veslíčko zachycuje zahradu před zámkem
Skiareál Troják
Záběry z otočné kamery umístěné v centru lyžařského středsika Troják. Pohled na parkoviště, svah A, restauraci a hotel.
Město Plzeň
Pohled na plzeňské sídliště Koštuka směrem na východ na Blovec..
Zdroj: meteoplzen.cz
Ski Karlov - areál Karlov
Pohled na začátek modré sjezdovky Vyhlídková.
Fotbalový klub Bystřice pod Hostýnem
Fotbalový stadión
Dolní Morava
Kamera u chaty Slaměnka v nadmořské výšce 1.116 m.n.m. přímo u horní stanice lanovky Sněžník
Přehrada Seč
Přehrada u autokempu Seč Pláž.